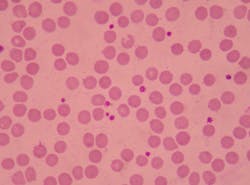
Dreamstime Xxl 120466771 64a588204831f Dreamstime Xxl 120466771 64a588204831f

AABB releases toolkit for implementation of cold-stored platelets and updates to the circular of information
AABB is pleased to make available a Toolkit for Implementation of Cold-Stored Platelets based on the recommendations in the recent Food and Drug Administration guidance, “Alternative Procedures for the Manufacture of Cold-Stored Platelets Intended for the Treatment of Active Bleeding when Conventional Platelets Are Not Available or Their Use Is Not Practical.”
The final guidance, issued for immediate implementation, permits blood establishments to adopt exceptions and alternatives to certain FDA requirements to support the manufacture of cold-stored platelets (CSP) without submitting a variance request to the agency under 21 CFR 640.120.
In addition, for facilities that manufacture CSP, AABB has updated the Circular of Information web page to include the language that must be added to the December 2021 Circular. Until such information can be included in the next version of the Circular, blood establishments that manufacture CSP must update their December 2021 Circular to provide adequate directions for the use of CSP. The FDA-recommended statements and information can be found under the section, “FDA Required Updates to the Circular.” The version date of December 2021 for the Circular must not be changed.